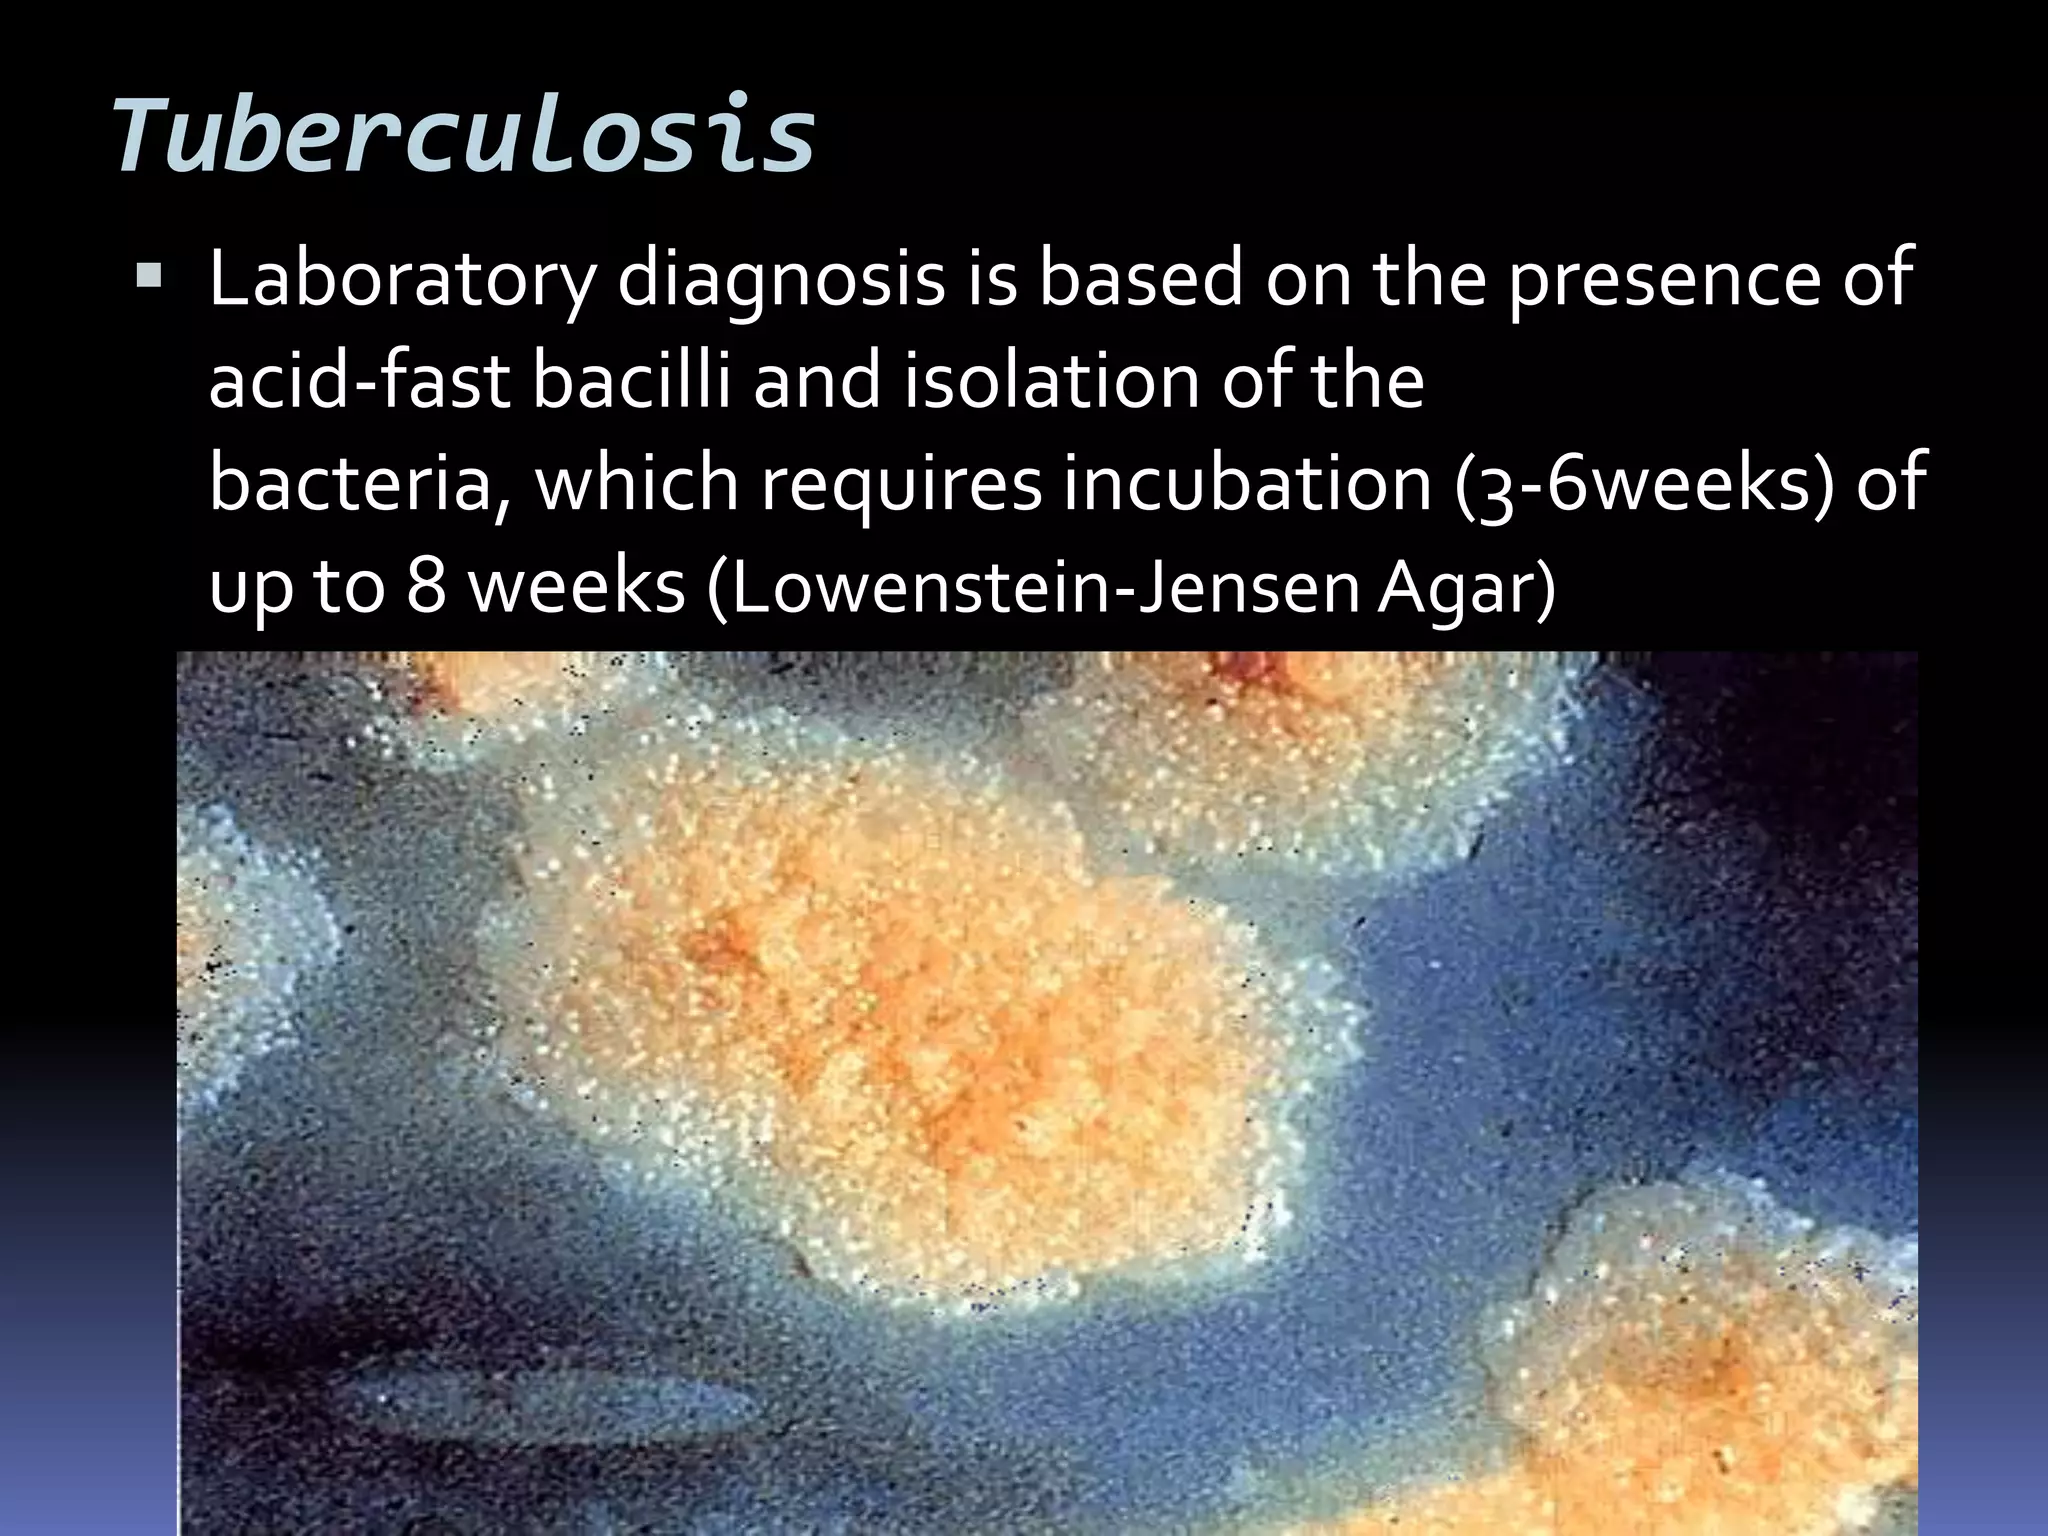
DNA hybridization
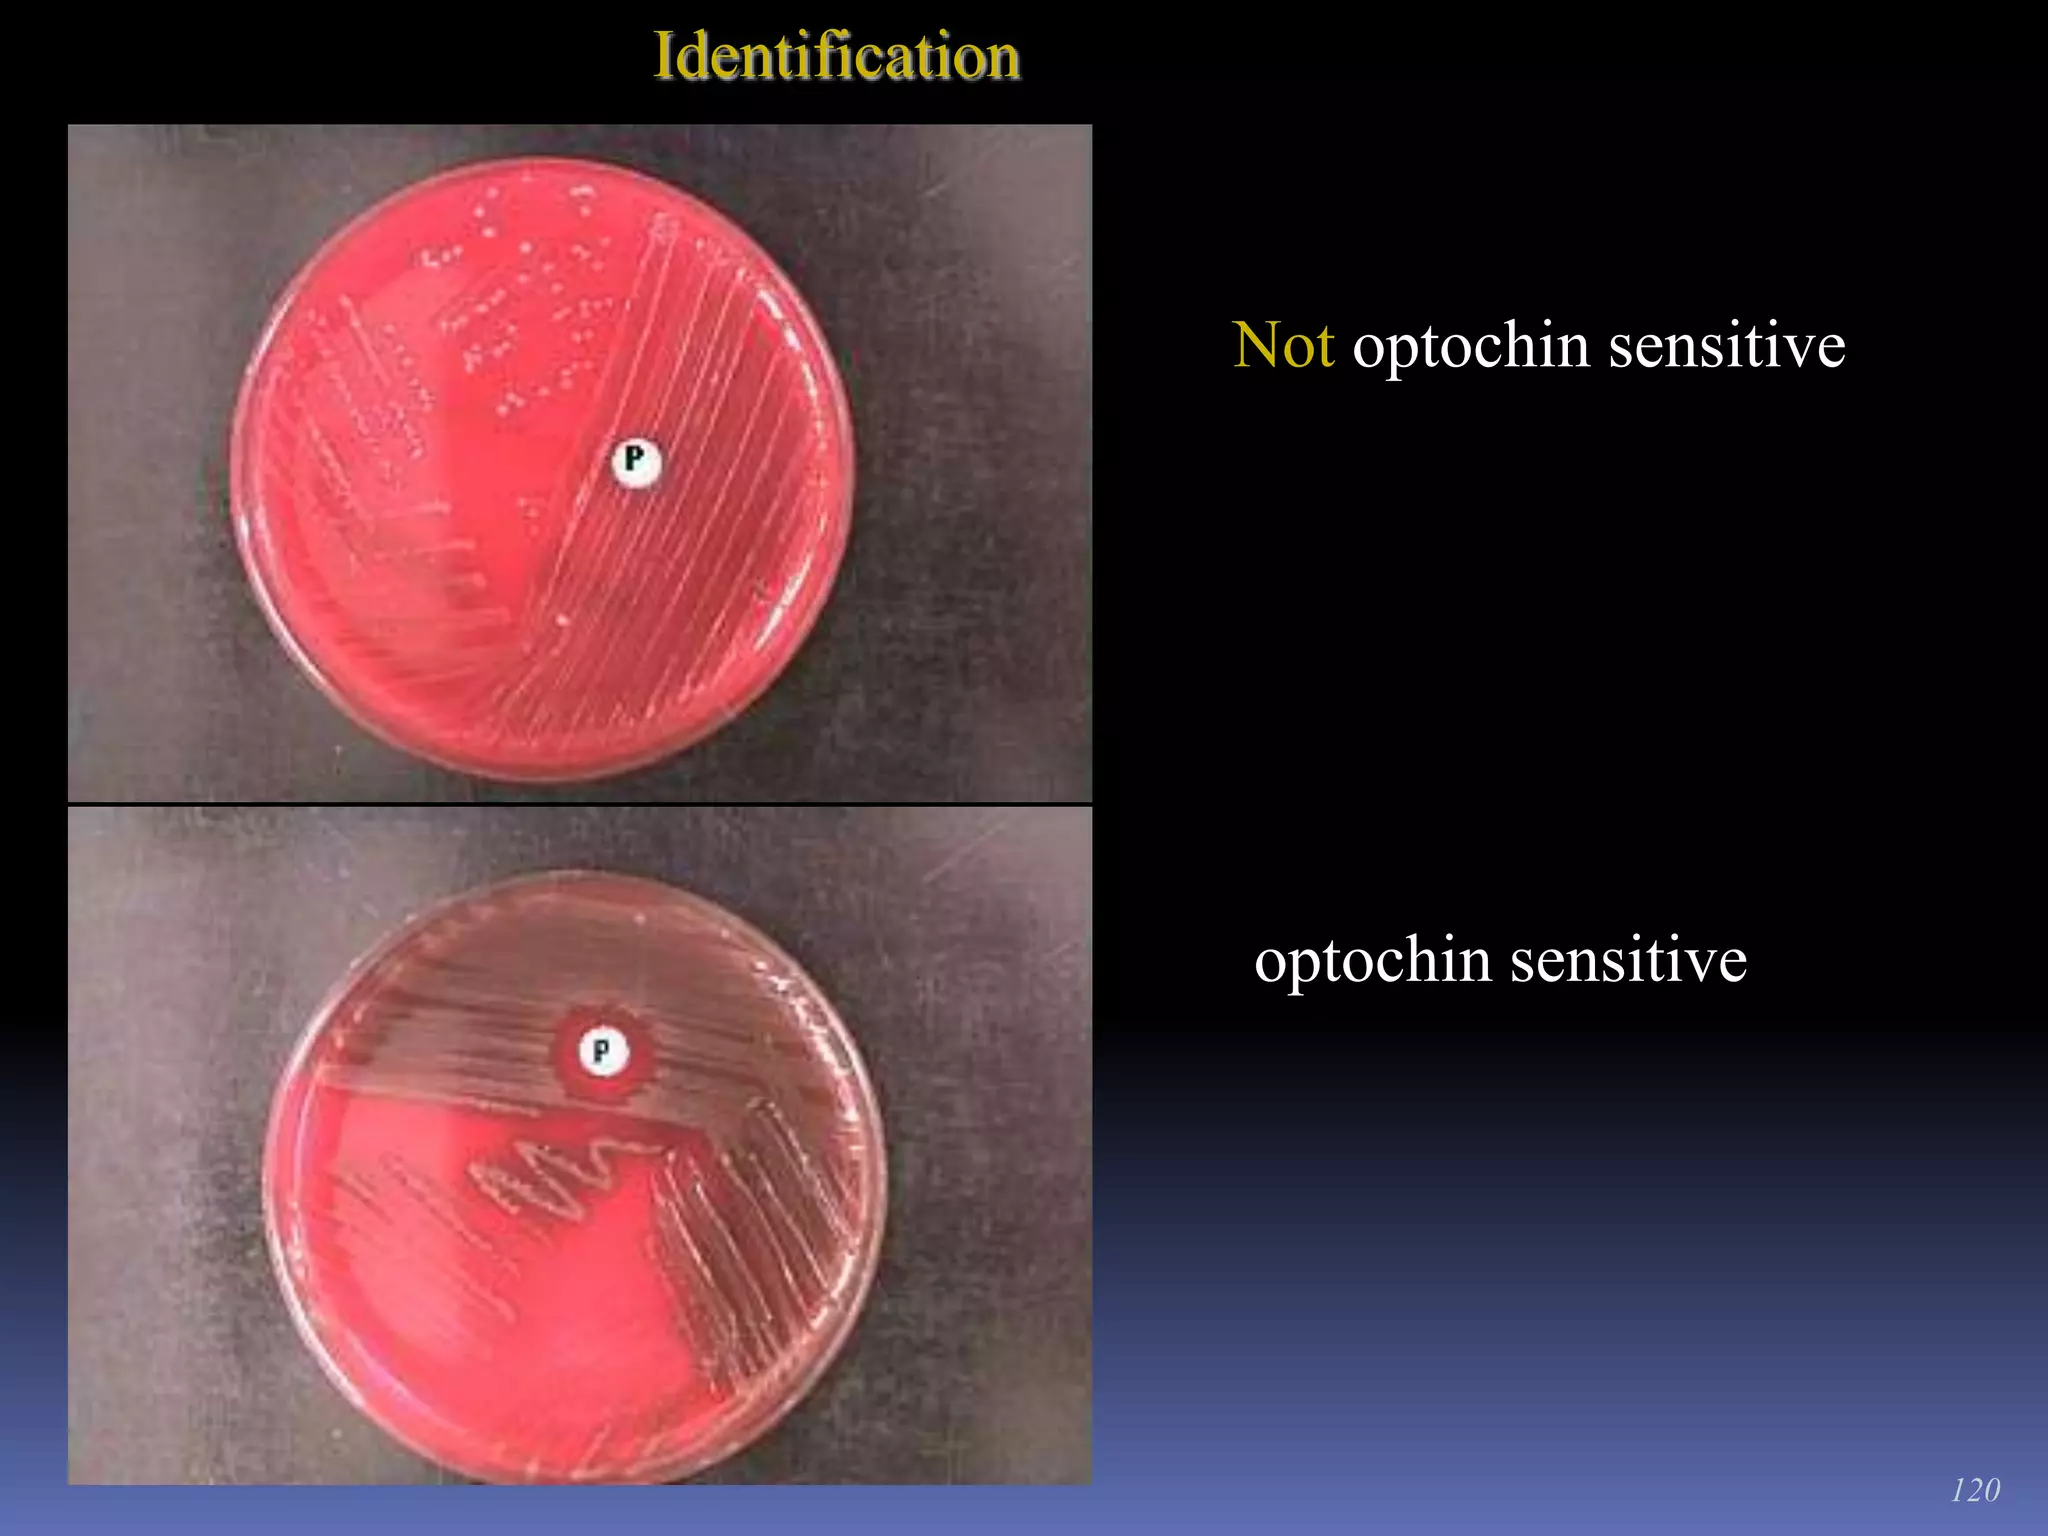
StainingWASHING AND DRYINGWash the slide with a gentle stream of running water.Tilt and place the slide on the slide rack to dry in the air.	Don’t place under the sun to dry.

The document discusses various microbial diseases that can infect the respiratory system, including the upper and lower respiratory tracts. Streptococcal pharyngitis (strep throat) is caused by group A streptococci and symptoms include sore throat and fever, with tonsillitis and otitis media sometimes occurring as well. Pertussis (whooping cough) is caused by the bacterium Bordetella pertussis and presents as severe coughing spells that can include an inspiratory whoop. Tuberculosis is caused by the acid-fast bacterium Mycobacterium tuberculosis and is an airborne disease that commonly affects the lungs.